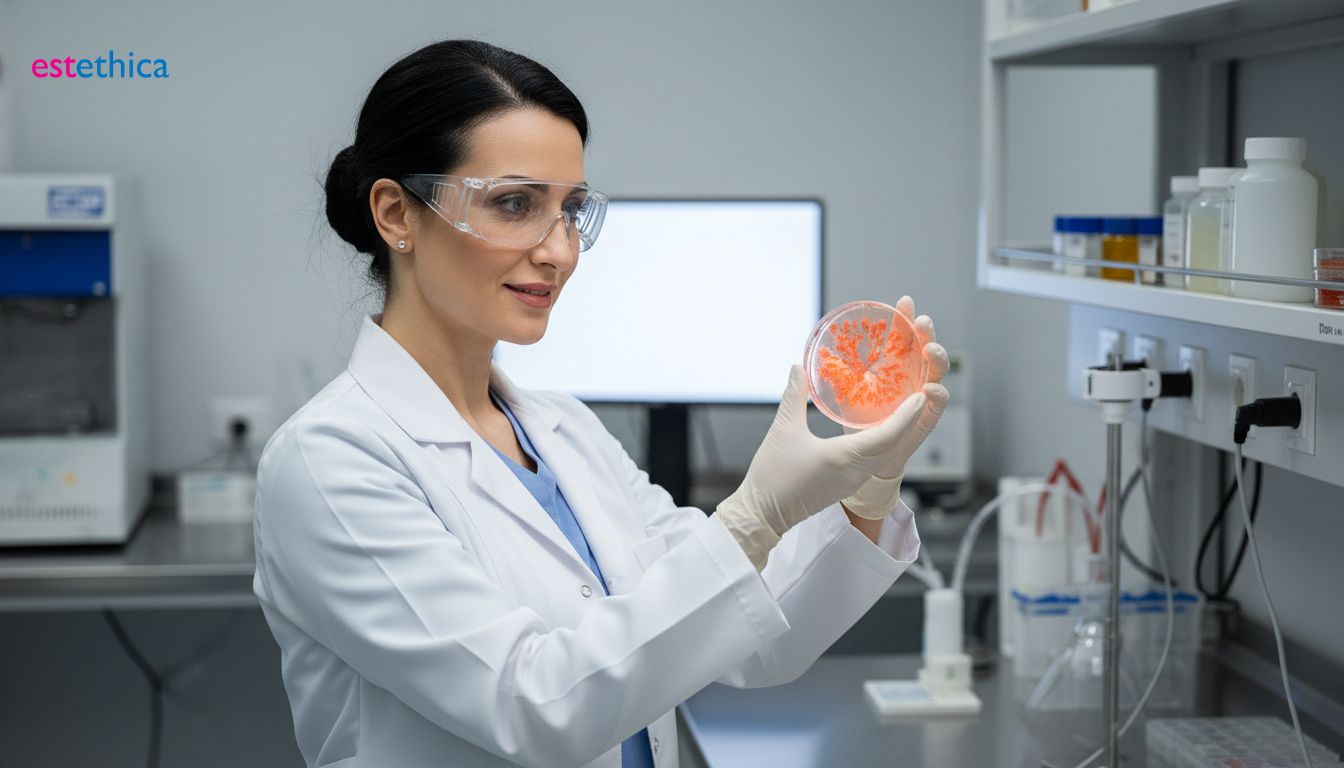
Kök Hücre Saç Ekimi Fiyatları ve Dikkat Edilmesi Gerekenler

Fibroblast kök hücre tedavisi ile saç dökülmesine kalıcı ve doğal çözümler sunuyoruz.
Saç dökülmesi, günümüzde pek çok kişinin karşılaştığı yaygın bir sorundur. Bu durum hem estetik kaygılara hem de özgüven kaybına yol açabilmektedir. Geleneksel yöntemlerin yetersiz kaldığı durumlarda, kök hücre tedavisi, özellikle de fibroblast kök hücre uygulamaları, saç dökülmesine karşı umut vaat eden yenilikçi bir çözüm olarak öne çıkmaktadır. Ataşehir'deki kliniğimizde, en son teknoloji ve uzmanlıkla sunduğumuz fibroblast kök hücre tedavisi ile saçlarınızın doğal canlılığına kavuşmanıza yardımcı oluyoruz. Bu tedavi, kendi hücrelerinizin gücünü kullanarak saç köklerini uyarır ve yeniden yapılanma sürecini destekler.
Kök Hücre ile Saç Dökülmesine Kesin Çözüm Mümkün Mü?
Saç dökülmesi, günümüzün yaygın problemlerinden biri haline gelmiştir. Genetik yatkınlık, yaşlanma süreci, hormonal dengesizlikler, yoğun stres veya çevresel faktörler gibi pek çok etken, saçların zayıflamasına ve dökülmesine yol açabilir. Geleneksel yöntemler genellikle dökülmenin belirtilerini hafifletmeye odaklanırken, daha köklü çözümler arayışı bilim ve teknolojinin ilerlemesiyle yeni kapılar açmıştır. Bu noktada, kök hücre ile saç dökülmesine çözüm arayışı, sorunun temel nedenlerine inmeyi hedefleyen yenilikçi bir yaklaşımdır. Vücudumuzda doğal olarak bulunan ve farklı hücre tiplerine dönüşebilme potansiyeli taşıyan kök hücreler, saç foliküllerini canlandırma ve yeni saç büyümesini teşvik etme potansiyeli sunmaktadır.
Kök Hücre Tedavisinin Saç Dökülmesindeki Rolü
Özellikle fibroblast kök hücre tedavisi, saç derisinin yenilenmesi ve onarımında gösterdiği etkinlikle öne çıkmaktadır. Fibroblastlar, bağ dokusunun temel yapı taşlarıdır ve cilt sağlığında kritik bir role sahiptirler. Saç derisine uygulanan bu özel kök hücreler, saç köklerini besleyerek güçlenmelerine yardımcı olur. Bu sayede saç telleri daha kalın, daha sağlıklı bir yapıya kavuşurken, dökülme süreci de belirgin şekilde yavaşlar. Bu yöntem, saç ekimi gibi cerrahi operasyonlara bir alternatif olabileceği gibi, mevcut tedavilere destekleyici olarak da kullanılabilir. Amacımız, kök hücre tedavisi ile hem saç dökülmesini durdurmak hem de saçların doğal olarak yeniden büyümesini sağlamaktır.
Fibroblast Tabanlı Kök Hücre Tedavisi Süreci
Kliniğimizde, fibroblast kök hücre tedavisi uygulamalarımızda hastalarımızın kendi hücrelerini kullanıyoruz. Kişiden alınan küçük bir deri örneği, laboratuvar ortamında çoğaltılarak zenginleştirilmiş fibroblast kök hücre tedavisi haline getirilir. Bu hazırlık sürecinin ardından, elde edilen bu yoğunlaştırılmış hücreler saç derisindeki ilgili bölgelere enjekte edilir. Bu gelişmiş tedavi, saç köklerini uyararak hem mevcut saçların ömrünü uzatır hem de yeni saçların sağlıklı bir şekilde çıkmasını destekler. Bu modern yaklaşım, kök hücre ile saç dökülmesine çözüm arayanlar için umut vaat eden bir yöntemdir. Ataşehir'deki merkezimizde, bu ileri teknolojiyi hastalarımızın hizmetine sunarak saç sağlığına kalıcı çözümler getirmeyi hedefliyoruz. Saç dökülmesine karşı sunduğumuz bu yenilikçi yaklaşımlar hakkında daha fazla bilgi almak için Saç Dökülmesine Kök Hücre Tedavisi: Doğal ve Kalıcı Saç Çıkarma Çözümleri başlıklı yazımızı inceleyebilirsiniz. Bu gelişmiş kök hücre tedavisi ile saçlarınızın eski sağlığına kavuşmasını destekliyoruz.

Fibroblast Teknolojisi Saç Tedavisinde Nasıl Kullanılır?
Saç dökülmesi, pek çok bireyin yaşam kalitesini olumsuz etkileyen yaygın bir sorundur. Geleneksel yöntemlerin yetersiz kaldığı durumlarda, tıp bilimi yenilikçi çözümler geliştirmeye devam etmektedir. Bunlardan biri de kök hücre tedavisi alanında çığır açan fibroblast teknolojisidir. Bu gelişmiş tedavi yöntemi, hastanın kendi vücudundan elde edilen hücrelerin gücünü kullanarak saçların yeniden canlanmasını ve güçlenmesini hedefler.
Fibroblast Teknolojisinin Temel Prensibi
Fibroblast kök hücre tedavisi, özünde hastanın kendi biyolojik materyallerini kullanma prensibine dayanır. Tedavi süreci, hastadan küçük bir doku örneğinin alınmasıyla başlar. Bu örnek genellikle kulak arkası gibi daha az görünür ve hassas bölgelerden temin edilir. Alınan bu doku, özel laboratuvar koşullarında işlenerek içindeki fibroblast hücreleri izole edilir ve çoğaltılır. Fibroblastlar, bağ dokusu oluşturan hücrelerdir ve cilt gençleştirme ile yara iyileşmesinde kilit rol oynarlar. Saç derisinde ise kan dolaşımını artırıcı, kolajen üretimini tetikleyici ve saç foliküllerini uyararak uyuyan kökleri aktive edici özelliklere sahiptirler. Bu zenginleştirilmiş fibroblast popülasyonu, saçın yeniden sağlıklı bir şekilde uzaması için gerekli ortamı yaratır.
Uygulama Süreci ve Beklentiler
Laboratuvarda çoğaltılan ve aktif hale getirilen fibroblast hücreleri, daha sonra saç derisindeki incelme ve dökülme görülen bölgelere dikkatlice enjekte edilir. Bu enjeksiyon işlemi genellikle mikro iğneleme teknikleri veya mezoterapi benzeri yöntemlerle gerçekleştirilir, böylece hücrelerin saç köklerine ulaşması kolaylaşır. Bu süreç, vücudun doğal iyileşme mekanizmalarını tetikler. Bir diğer gelişmiş uygulama olan Kök Hücre Tedavisi: İstanbul Ataşehir'de Doğal Saç Büyümesi ve Yeniden Canlandırma gibi yöntemler de benzer prensiplerle çalışarak saç köklerini destekler. Kök hücre tedavisi ile elde edilen sonuçlar kişiden kişiye değişiklik gösterebilse de, genel beklenti mevcut saçların güçlenmesi, dökülmenin azalması ve yeni saç tellerinin oluşumunun desteklenmesidir. Bu yenilikçi yaklaşım, özellikle genetik yatkınlık veya yaşa bağlı saç kayıplarında umut vaat eden bir seçenektir. Fibroblast kök hücre tedavisi, saç dökülmesine karşı geliştirilen ileri teknolojilerden biridir. Bu tedavinin bir diğer önemli yönü, kişinin kendi hücrelerinin kullanılması sayesinde alerjik reaksiyon riskinin minimumda tutulmasıdır. Bu sayede daha güvenli ve etkili bir saç restore süreci mümkün olmaktadır. Kök hücre tedavisi, saç foliküllerini yenileyerek daha sağlıklı saç büyümesini teşvik eder.
Fibroblast kök hücre tedavisi, saç dökülmesine karşı yenilikçi bir çözüm sunarken, sabır ve düzenli takip gerektiren bir süreçtir. Uygulama sonrası elde edilen sonuçlar zamanla belirginleşir ve saçın doğal döngüsüne uyum sağlar. Bu yöntem, kök hücre tedavisi alanındaki ilerlemelerin somut bir örneğidir.
Kök Hücre Saç Ekimi Fiyatları ve Dikkat Edilmesi Gerekenler
Kök hücre saç ekimi, günümüzde saç dökülmesine karşı geliştirilen en yenilikçi yaklaşımlardan biridir. Ancak, bu gelişmiş tedavi yönteminin fiyatlandırması çeşitli faktörlere bağlı olarak değişiklik göstermektedir. Kök hücre saç ekimi fiyatları, kişiye özel olarak belirlenir. Çünkü her bireyin saç dökülme paterni, derecesi ve ihtiyaç duyduğu tedavi seans sayısı farklıdır. Tedavinin kapsamı, uygulanan kök hücre miktarının yoğunluğu ve kliniğin sunduğu ek hizmetler de fiyatlandırmada rol oynayan önemli unsurlardır. Ataşehir'de bulunan estetik ve cerrahi tıp merkezimizde, her hastamız için detaylı bir ön değerlendirme yaparak en uygun tedavi planını ve buna bağlı olarak net bir fiyat teklifi sunmaktayız. Bu ön görüşmeler, hem sizin beklentilerinizi anlamamızı sağlar hem de tedavi süreci hakkında şeffaf bir bilgilendirme yapmamıza olanak tanır. Unutmamak gerekir ki, kök hücre tedavisi sadece saç köklerini uyarmakla kalmaz, aynı zamanda var olan saç köklerini de güçlendirerek daha sağlıklı ve dolgun saçlara kavuşmanıza yardımcı olur.
Kök Hücre Saç Ekimi Süreci ve Maliyetleri
Kök hücre tedavisi uygulaması, genellikle hastanın kendi vücudundan alınan yağ dokusu veya kan hücrelerinin özel işlemlerden geçirilerek zenginleştirilmesi ve ardından saç derisine enjekte edilmesi prensibine dayanır. Bu işlem, cerrahi bir müdahale gerektirmez ve iyileşme süreci oldukça hızlıdır. Tedavinin maliyetini etkileyen bir diğer unsur ise kullanılan teknolojinin kalitesidir. Kliniğimizde, en son teknolojiye sahip cihazlar ve sterilizasyon standartları ile kök hücre tedavisi uygulaması gerçekleştirilmektedir. Bu sayede, hem tedavi etkinliği maksimize edilir hem de hasta güvenliği ön planda tutulur. Fibroblast teknolojisi kullanılarak elde edilen bu zenginleştirilmiş hücreler, saç köklerinin yenilenmesini tetikleyerek doğal saç büyümesini destekler. Bu yenilikçi yaklaşım, saç dökülmesine karşı etkili bir çözüm sunarken, uzun vadeli sonuçlar vaat eder. Bu bağlamda, kök hücre tedavisi ile ilgili daha detaylı bilgi edinmek ve saçlarınızdaki canlanmayı deneyimlemek için kliniğimizle iletişime geçebilirsiniz. Eğer cilt gençleştirme ve onarım alanındaki diğer yenilikçi yöntemler hakkında da bilgi almak isterseniz, Yenilikçi Kök Hücre ve Fibroblast Tedavileriyle Cilt Gençleştirme ve Onarım başlıklı yazımızı inceleyebilirsiniz.
Tedavi Öncesi ve Sonrası Dikkat Edilmesi Gerekenler
Bu gelişmiş kök hücre tedavisi için karar vermeden önce dikkat edilmesi gereken bazı önemli noktalar bulunmaktadır. Öncelikle, uygulamanın mutlaka alanında uzmanlaşmış, sertifikalı doktorlar ve deneyimli bir ekip tarafından yapılması esastır. Tedavide kullanılacak malzemenin kalitesi, hijyenik ortam ve steril koşullar, hem tedavinin başarısı hem de hasta sağlığı açısından kritik öneme sahiptir. Fibroblast kök hücre tedavisi öncesinde doktorunuzla beklentilerinizi ve tedavi sürecini detaylı bir şekilde konuşmanız, olası sonuçlar hakkında net bir fikir edinmenizi sağlayacaktır. Tedavi sonrasında ise doktorunuzun önerdiği bakım talimatlarına uymanız, iyileşme sürecini hızlandıracak ve elde edilen sonuçların kalıcılığını artıracaktır. Doğru uygulandığı takdirde, fibroblast kök hücre tedavisi saç dökülmesine karşı oldukça etkili bir yöntemdir ve kök hücre ile saç dökülmesine çözüm arayanlar için umut vaat etmektedir. Ayrıca, fibroblast kök hücre tedavisi ile elde edilen olumlu sonuçlar, uygulamanın etkinliğini desteklemektedir. Bu anlamda, kök hücre ile saç dökülmesine çözüm arayışınızda doğru adımları atmak için uzman görüşü almak önemlidir.
Saç Dökülmesi Tedavisi: Fibroblast Kök Hücre Farkı Nedir?
Günümüzde piyasada saç dökülmesi tedavisi için sunulan birçok farklı yaklaşım bulunmaktadır. Geleneksel yöntemler genellikle mevcut saç tellerini güçlendirmeye ve dökülme hızını yavaşlatmaya odaklanırken, fibroblast kök hücre tedavisi çok daha yenilikçi bir yaklaşım sunar. Bu tedavi, doğrudan saç köklerinin kendisini yenileyerek ve yeniden büyümeyi teşvik ederek daha kalıcı ve etkili bir çözüm hedeflemektedir. Bu, klasik saç ekimi yöntemlerinden temel bir farktır; zira saç ekimi, saç köklerinin donör bölgeden alınıp seyrelmiş alanlara nakledilmesi prensibine dayanır.
Fibroblast Kök Hücre Tedavisinin Temel Prensipleri
Buna karşılık, fibroblast kök hücre tedavisi, hastanın kendi vücudundan elde edilen kök hücreleri kullanır. Bu hücreler, uygulandıkları bölgede doğal bir iyileşme ve doku yeniden yapılanma sürecini tetikler. Bu özel kök hücre tedavisi, saç foliküllerinin yaşam döngüsünü uzatmayı, saç tellerinin çapını artırmayı ve böylece genel saç yoğunluğunu iyileştirmeyi amaçlar. Fibroblast hücrelerinin, saç derisindeki dokuların gençleşmesine katkıda bulunması, saçların daha sağlıklı, güçlü ve dirençli olmasına olanak tanır. Bu nedenle, kök hücre ile saç dökülmesine çözüm arayanlar için umut vadeden bir yöntemdir.
Geleneksel Yöntemlerden Ayrılan Yönleri
Fibroblast kök hücre tedavisi, saç derisinin hücresel düzeyde yenilenmesini sağlayarak, saç dökülmesinin altında yatan nedenlere yönelik bir müdahale sunar. Bu, semptomları yönetmeye odaklanan yöntemlerden sıyrılmasını sağlar. Özellikle ileri derecede saç seyrelmesi yaşayan bireylerde bu kök hücre ile saç dökülmesine çözüm arayışı, etkili sonuçlar elde etme potansiyeli taşır. Kliniğimiz, İstanbul'un Ataşehir bölgesinde bu gelişmiş teknoloji ile hizmet vermektedir. Saç dökülmesine karşı sunduğumuz bu yenilikçi yaklaşım hakkında daha fazla bilgi edinmek isterseniz, Eksozom ile Kök Hücre Tedavisi: Hücresel Yenilenme ve İyileşme Yolculuğu başlıklı yazımızı inceleyebilirsiniz. Bu, kök hücre tedavisi alanındaki bir diğer önemli gelişmeyi kapsamaktadır.

Fibroblast Kök Hücre Tedavisi: Saç Derisi Yenilenmesi ve Onarımı İçin Yenilikçi Yaklaşım
Fibroblast teknolojisi, saç derisinin yenilenmesi ve onarımında gösterdiği etkinlikle öne çıkan yenilikçi bir kök hücre saç tedavisi yöntemidir. Bu özel yaklaşım, saç köklerini uyararak doğal canlılığı geri kazandırmayı hedefler. Tedavide hastanın kendi biyolojik materyalleri kullanılarak kişiye özel ve güvenli bir uygulama sunulur.
Saç dökülmesine karşı sunduğumuz bu gelişmiş tedavi, incelme ve dökülme sorununun temel nedenlerine inmeyi amaçlar. Laboratuvarda çoğaltılan aktif fibroblast hücreleri, saç derisindeki sorunlu bölgelere dikkatlice enjekte edilerek yeniden yapılanma süreci desteklenir.
Ataşehir'deki kliniğimizde, en son teknoloji ve uzmanlıkla sunduğumuz fibroblast kök hücre tedavisi, saç dökülmesine karşı umut vaat eden bir çözümdür. Uzman ekibimiz, bu yenilikçi tedaviyi hastalarımızın ihtiyaçlarına göre kişiselleştirerek maksimum fayda sağlamayı hedefler.
Tedavilerimizde hastalarımızın kendi hücrelerini kullanmamız, doğal bir iyileşme süreci sağlayarak güvenliği ön planda tuttuğumuzun bir göstergesidir. Fibroblast kök hücre tedavisi ile saçlarınızın doğal yapısını güçlendirerek kalıcı çözümler sunmayı amaçlıyoruz.
Fibroblast Kök Hücre Saç Tedavisi Uygulama Süreci ve Güvenilirlik
Fibroblast kök hücre tedavisi, özünde hastanın kendi biyolojik materyallerini kullanma prensibine dayanır. Bu, tedavi sürecinin hem güvenli hem de vücutla uyumlu olmasını sağlar. Kliniğimizde, bu ileri teknoloji uygulamaları uzman hekimlerimiz tarafından titizlikle gerçekleştirilir.
Uygulama süreci, hastadan alınan küçük bir doku örneğinin laboratuvarda fibroblast hücrelerinin çoğaltılması ve aktif hale getirilmesiyle başlar. Bu hazırlık sürecinin ardından, çoğaltılan hücreler saç derisindeki hedef bölgelere enjekte edilir.
Fibroblast kök hücre tedavisi yorumları, genellikle tedavinin etkinliği ve hasta memnuniyeti üzerine odaklanmaktadır. Saç derisinin yenilenmesi ve onarımında gösterdiği başarı, hastalarımızın özgüvenlerinin artmasına katkı sağlamıştır.
Bu gelişmiş kök hücre tedavisi için karar vermeden önce dikkat edilmesi gereken bazı önemli noktalar bulunmaktadır. Tedavinin kişiye özel planlanması, süreci ve beklentileri doğru yönetmek, başarılı sonuçlar elde etmenin temelidir.
